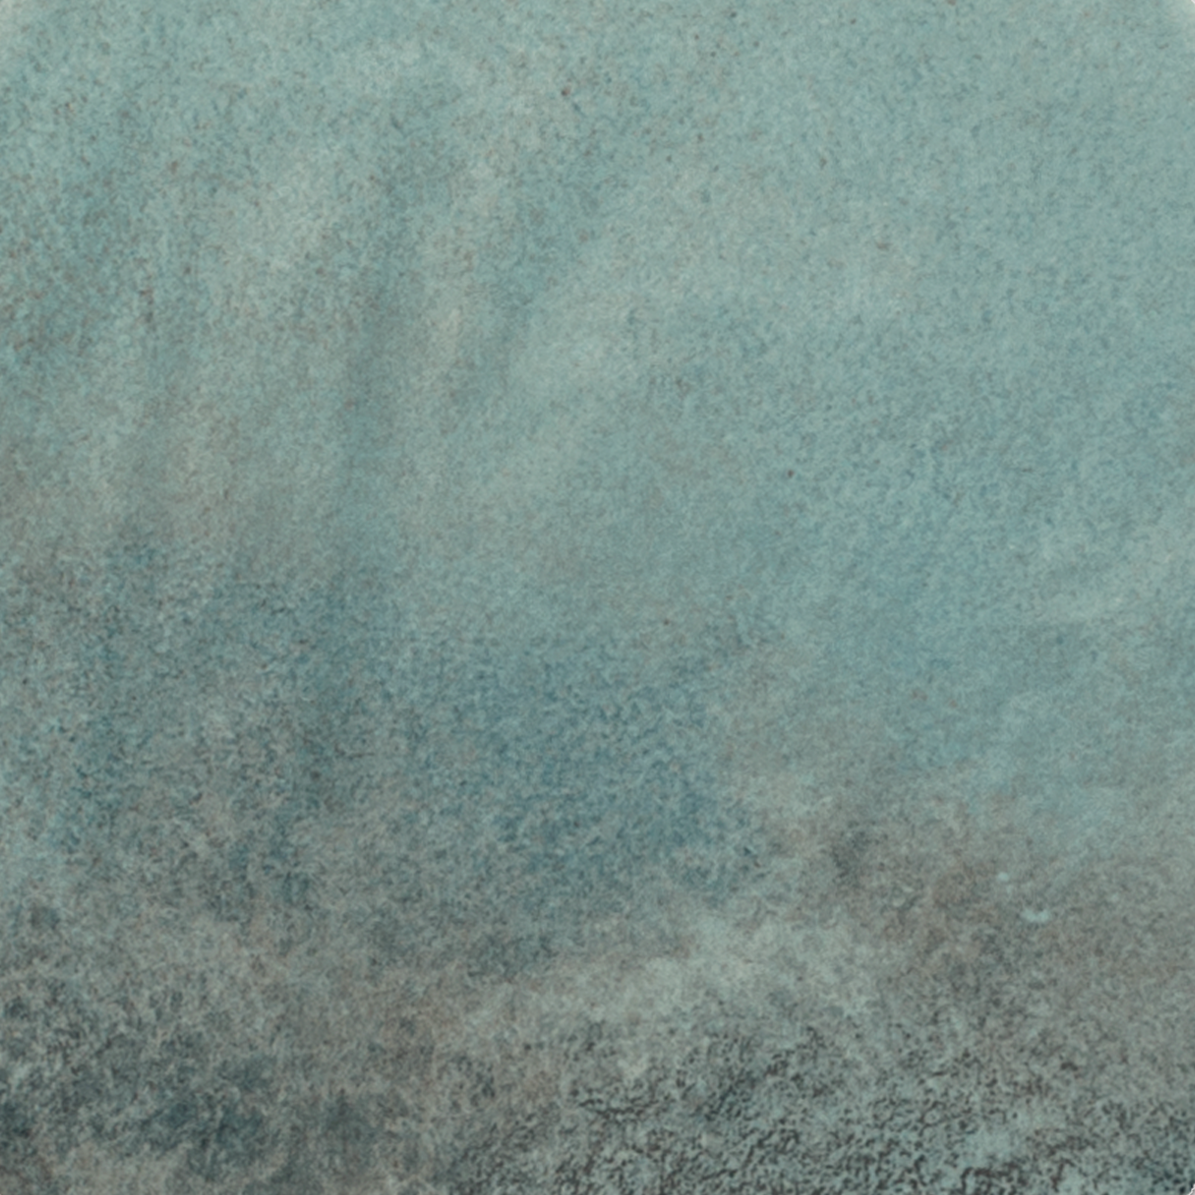
Green Moon ceramic tile from the Elon collection with a natural stone look available at Surface Group online tile store

All collections

Gray Marble Mosaic
502 products

Gray Marble Tile
774 products

Gray Opal
2 formats

Gray Opal Field Tile
2 products

Gray Opal Tile Accessory
2 products

Green Ceramic Tile
0 products

Green Classic Medley Field Tile
4 products

Green Ginkgo Deco Xl
1 products

Green Ginkgo Deco Xl Porcelain Deco Tile
1 products

Green Glass Tile And Mosaic
759 products

Green Hampton E
2 formats

Green Hampton E Field Tile
1 products

Green Hampton E Tile Accessory
2 products

Green Marble Mosaic
73 products

Green Marble Tile
108 products

Green Medley Field Tile
15 products

Green Medley Mosaic
1 products

Green Medley Porcelain Tile
16 products

Green Metallica Field Tile
1 products

Green Metallica Porcelain Tile
1 products

Green Minimal Medley Field Tile
5 products
Green Moon
2 formats

Green Moon Field Tile
2 products

Green Moon Tile Accessory
1 products

Green Pop Medley Field Tile
3 products

Green Rock Medley Field Tile
3 products

Green TDM Onyx Porcelain Tile
11 products

Green Tele Di Marmo Onyx Field Tile
7 products

Green Tele Di Marmo Onyx Mosaic
4 products

Green Timeless
2 products

Green Timeless Field Tile
2 products

Greige Controfalda Stone Project Field Tile
8 products

Greige Falda Stone Project Field Tile
8 products

Greige Fondo Oros Greek Field Tile
7 products

Greige Oros Greek Field Tile
9 products

Greige Oros Greek Mosaic
2 products

Greige Oros Greek Porcelain Tile
11 products

Greige Split Face Oros Greek Field Tile
2 products

Greige Stone Project Field Tile
16 products

Greige Stone Project Mosaic
2 products

Greige Stone Project Porcelain Tile
21 products

Greige Stone Project Wall Tile
3 products

Grey Acustico 12 Field Tile
3 products

Grey Acustico 12 Mosaic
1 products

Grey Acustico Porcelain Tile
4 products

Grey Ash Millelegni Field Tile
3 products

Grey Ash Millelegni Porcelain Tile
3 products

Grey
1 products
Tile






